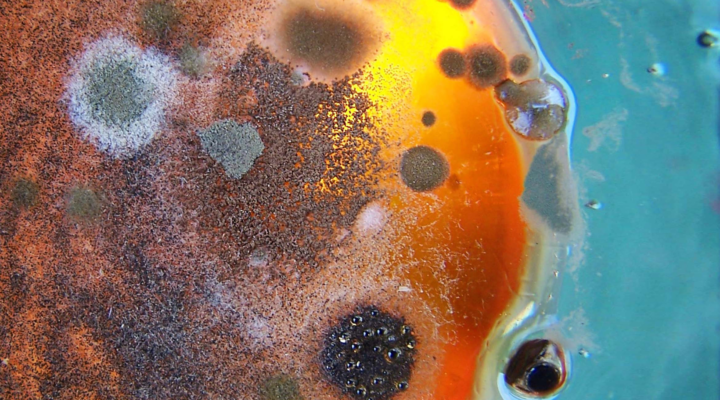
pelėsiniai grybai

Liaudiškos priemonės nuo pelėsio: geriausi pelėsio valikliai
Pelėsis – pilkasis ir nemalonusis namų kenkėjas. Jis erdves okupuoja labai greitai, tačiau išprašyti šį nelauktą svečią – kur kas sunkiau, nei tikėjotės. Pelėsio plotai dažnai „papuošia“ namų sienas, grindis, langų rėmus ir pačius langus bei kitus paviršius. Taigi, atrodytų, pelėsį reikėtų naikinti pirmiausia dėl